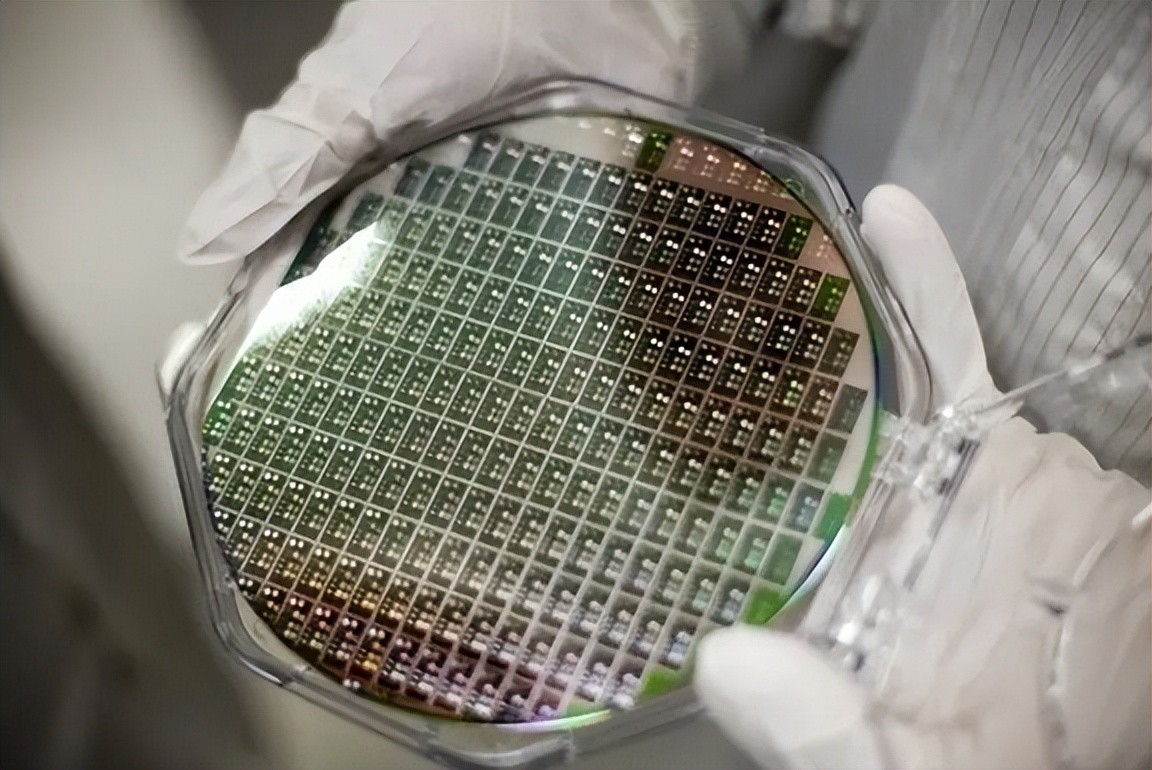

俄企业宣布增产锗元素,俄专家:可能向欧美出口,但取代不了中国
俄企业宣布增产锗元素,俄专家:可能向欧美出口,但取代不了中国

据悉,本月初中国商务部宣布对镓和锗两种元素实行出口管制措施,自8月1日起开始执行;这件事在国际上引发舆论热议,又因为镓、锗元素是制造半导体芯片和精密仪器设备所需的关键材料,日韩、欧盟和美国等国家高度依赖从中国进口镓和锗元素,这次管制将会对其产生很大影响。消息人士称因为中国对镓元素出口的市场占有率极高(约为96%),西方当前只能寻求从其他渠道扩大进口另一种锗元素,恰在此时俄罗斯企业却宣布扩大生产锗元素。

英媒在6日的报道提到,宣布要扩大生产的公司是俄罗斯国家技术集团旗下施瓦贝控股企业,这家公司在苏联解体后吸收了很多国企,拥有锗开采提炼的完整工业链和技术。但因为其开采成本和竞争力落后,该企业每年生产的锗元素出口率很低,自用率也不高。所以当前趁中国管制锗元素出口的机会,施瓦贝控股会在锗价格上涨之际扩大开采和生产。尽管该企业打的旗号是“满足俄罗斯国内工业自用”,但结合现实仍有不少人相信他们会借机向西方出口,毕竟俄方国内需求量有限。
10日,俄罗斯《专家》杂志网站发表一篇文章,提及中方管制以及俄罗斯增产锗元素事件。俄媒表示中国管制的材料用途比较广泛,红外光学、光纤通信、太阳能电池等领域都会有这些需求,所以镓和锗将变得更加昂贵;《公司》杂志刊文称,俄国内工业专家哈扎诺夫认为施瓦贝控股“可能会和西方国家做锗元素出口的交易”,欧美也会寻求向俄罗斯进口。但他话锋一转又表示,即使如此俄罗斯也很难取代中国在该市场上的地位,中方在该领域出口原材料能力和积累太强了。

有分析则认为,哈扎诺夫的言论侧重于比较俄罗斯和中国关于锗元素的“生产力”问题;因为俄方仍然沿用苏联上世纪70年代的锗开采和提纯技术,流程复杂且成本高昂,在之前的国际市场上价格几乎无人问津。所以当前俄方是借着中国管制锗价格迅速上涨的风头才获得出口的机会,这意味着一旦中国不再管制,价格下跌后俄罗斯的出口能力将迅速衰落;所以如果不更新技术,俄方想取代中国的地位几乎是不可能的。

值得一提的还有,之前报道提及俄罗斯也有将镓元素增产的趋势,“俄铝”公司表示,其一家氧化铝工厂每年能够生产6吨镓,但拒绝透露目前的产量和供应目的地;不过俄方镓元素即使全部供应西方,也满足不了西方的小部分需求。对此有评论称:“关键不是俄罗斯能否取代中国地位的问题,而是他们为什么要对外出口欧美用于制造半导体的材料?别忘了在乌克兰战场上双方仍然是‘敌对国’,且西方至今仍向俄罗斯进行半导体禁运以及对乌克兰提供武器,这种做法并不明智。”
标签:


















